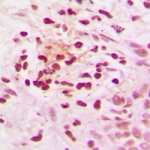

(1 Publications)
(1 Publications)